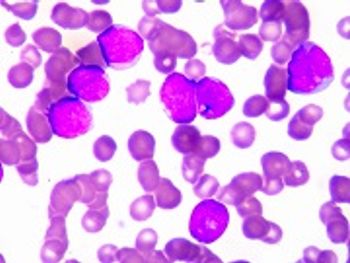

Gene overexpressed in AML may offer new target for halting the spread of cancer.

Gene overexpressed in AML may offer new target for halting the spread of cancer.

Preclinical studies of a combination therapy with birinapant and p38 inhibitors show promise treating AML.

Evomela is the first drug approved for a high-dose conditioning indication of multiple myeloma.

Evomela is the first product to be FDA-approved for a high-dose conditioning indication for multiple myeloma.

Radiotherapy and panobinostat show promise treating glioblastoma.

The Leukemia & Lymphoma Society and Walgreens have announced the launch of an innovative collaboration designed to further advance cancer therapies and address the changing treatment model facing patients with blood and other cancers.

New chemoimmunotherapy drugs found to improve survival in patients with CLL.

Combination therapy with lenalidomide and dexamethasone plus bortezomib in multiple myeloma patients shows significant improvement.

A study found positive outcomes of dose-attenuated combination therapy with lenalidomide and dexamethasone plus bortezomib in multiple myeloma patients.

The cost of treating pediatric cancer can force higher-income families into poverty.

The FDA has approved Janssen Biotech's ibrutinib capsules for treatment-naïve patients with chronic lymphocytic leukemia.

Caregivers should closely monitor hepatitis C infection in patients undergoing chemotherapy.

ONC201 caused p53-independent cell death and cell cycle arrest in lymphoma and acute leukemia patient samples.

Ibrutinib (Imbruvica) is the first FDA-approved chemotherapy-free treatment for patients with chronic lymphocytic leukemia (CLL).

Ibrutinib (Imbruvica) is the first chemotherapy-free treatment for first line CLL patients approved by the FDA.
The application includes new data for pediatric and adolescent patients with Philadelphia chromosome-negative relapsed or refractory B-cell precursor acute lymphoblastic leukemia (ALL).

Blincyto is currently the only FDA-approved bispecific CD19-directed CD3 T cell engager immunotherapy available for the treatment of Philadelphia chromosome-negative relapsed or refractory B-cell precursor ALL.

Nanoparticles acting as cancer drug delivery vehicles show promise in eliminating tumors.

With the increasing use of novel therapies for multiple myeloma, benchmarks are needed to assess the value of these options.

Researchers created a model framework to compare costs of 7 common regimens to treat relapsed and/or refractory multiple myeloma.

The management of individual chemotherapy regimens by pharmacists improves safety by reducing medication errors.

Early lineage T cells show promise in the treatment of acute lymphoblastic leukemia.

Proposal includes giving insurers the ability to withhold products from formularies if the cost of cancer drugs do not represent good value.

Analysts believe T-cell therapies must first show curative properties in blood cancer treatment to justify the price tag.

Analysts believe T-cell therapies must first show curative properties in blood cancer treatment to justify the cost.